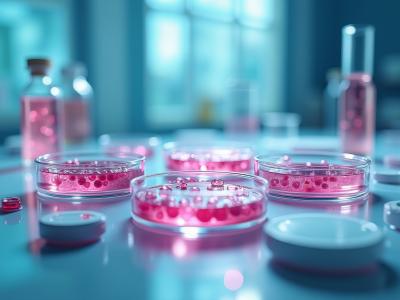
La médecine régénérative pourrait devenir une option viable dans le traitement du muscle squelettique vieillissant (Visuel Adobe Stock 1213280381)

La MÉDECINE RÉGÉNÉRATIVE au secours du muscle vieillissant
La médecine régénérative pourrait devenir une option viable dans le traitement du muscle squelettique vieillissant, selon cette équipe de biologistes de l’Université métropolitaine de Tokyo, qui réussit ici la première transplantation de myoblastes et apporte une première preuve de concept de l’apport de myoblastes cultivés, dans des tissus sains. Ces travaux, présentés dans la revue Frontiers in Cell and Developmental Biology, apportent notamment un espoir dans la lutte contre un fardeau sanitaire croissant, la sarcopénie.
Pour continuer à lire cette actualité, vous devez être membre Premium.

Je souhaite devenir membre PREMIUM
Accèdez sans limite aux 15 000 actualités du site et recevez gratuitement chaque semaine, la Newsletter Santé log avec les actus Santé à ne pas manquer !

Je suis déjà
membre PREMIUM
Devenez membre PREMIUM
Accèdez sans limite aux 15 000 actualités du site
et recevez gratuitement chaque semaine,
la Newsletter Santé log avec les actus Santé à ne pas manquer !

Je suis déjà membre PREMIUM
Autres actualités sur le même thème
L’EXERCICE PHYSIQUE préserve les femmes de l’arthrite plus tard dans la vie
Actualité publiée il y a 8 années 4 moisFRACTURE OSSEUSE : Leur incidence pourrait doubler d’ici 2050
Actualité publiée il y a 2 années 9 moisTENDINITE : Les corticoïdes peuvent aider, sous condition d'une prescription "chronométrée"
Actualité publiée il y a 8 années 5 moisMAL de DOS : La stimulation des ganglions de la racine dorsale inhibe la douleur chronique
Actualité publiée il y a 7 années 4 mois
ABONNEMENT PREMIUM
Accédez sans limite à plus de 15 000 actualités




